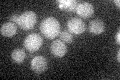
YNR036C
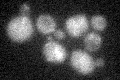
YNR036C

View description
Mitochondrial protein; may interact with ribosomes based on co-purification experiments; similar to E. coli and human mitochondrial S12 ribosomal proteins
Localization:
Intensity:
Fold change:
Significance:
-
C’ GFP library in SD
below threshold16.65 -
N' NOP1pr-GFP in SD

mitochondria59.5507 -
N' TEF2pr-mCherry in SD

missing0 -
N' NATIVEpr-GFP in SD

below threshold17.9983 -
N' TEF2pr-VC and Cyto-VN in SD

#N/A0 -
C’ GFP library in SD+DTT

cytosol15.810.94No -
C’ GFP library in SD+H2O2
cytosol14.60.87No -
C’ GFP library in Starvation Media

cytosol17.851.07No -
C’ GFP library on the background of Pup2-DaMP

below threshold -
C’ GFP library on the background of CCT mutant

below threshold15.94870.957298No
